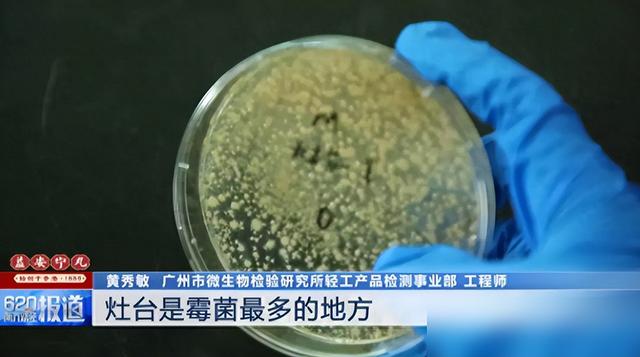

你以为擦得锃亮的灶台真干净?
其实暗藏百万级细菌!
最近一条“抽油烟机滤网比马桶脏10倍”的消息,让无数家庭主妇惊出一身冷汗——原来每天做饭的厨房,竟藏着这么大的健康隐患!
厨房油污:藏在烟火气里的“生化武器”广州市微生物检验研究所的检测数据让人倒吸冷气:普通家庭三天未清理的灶台,每平方厘米菌落总数能突破6.9万,黄曲霉菌、大肠杆菌、沙门氏菌在油垢里20分钟就能繁殖一代;连续用3个月的抽油烟机滤网,菌落数直接是马桶座圈的10倍!

更吓人的是,这些油垢里的细菌还会“进化”——反复用清洁剂轰炸后,它们能形成耐药性生物膜,越洗越顽固。
炒菜时160℃的油温一激,这些细菌就跟着油烟“坐”上“空中快车”,在厨房漫天飞。
钟南山院士早就提醒过,厨房PM2.5浓度能是平时的十几倍甚至几百倍,长期接触油烟的40-60岁女性,患肺癌、乳腺癌的风险直接增加2-3倍。
网友们的吐槽更扎心:“擦灶台弯腰半小时,油垢没擦掉,手倒被清洁剂烧得发红”“抹布越擦越脏,三天不换能闻见霉味”……这哪是做饭,简直是和细菌“贴身肉搏”!
厨房清洁难,难在“既要强去污,又要够安全”。
传统清洁剂要么刺鼻伤手,要么残留像“洗涤界苏丹红”;钢丝球擦抽油烟机,还会刮出肉眼看不见的重金属污染。
但最近,京东超市联合绿伞推出的“化油为水油烟净”,直接给这场“清洁大战”按下了“快进键”。
这瓶“黑科技”到底有多猛?

它用独家专利技术,能直接渗透、瓦解、乳化油垢,喷一次相当于手动擦10下,陈年油垢“唰”地就化成水。
更关键的是,它不腐蚀抽油烟机涂层,不刺激皮肤,抑菌率还高达99.99%,连蒸箱、烤箱外表面都能用。
环保党也放心——100%可回收材料,用完不污染环境。
为了让大家“用得安心”,京东超市还搞了个行业首创的“洗不净包赔”服务:4月15日到5月5日,买了这瓶油烟净的用户,按说明用了15天内不满意,剩一半以上还能全额退款。

网友调侃:“这哪是卖产品,简直是给家务小白‘上保险’!”
从“做饭容易打扫难”到“轻松拿捏烟火气”:我们需要怎样的生活科技?厨房清洁的痛点,藏着中国家庭最真实的生活状态——既要“人间烟火”,又要“岁月静好”。
以前总说“做饭是爱,打扫是痛”,现在这瓶油烟净和“洗不净包赔”服务,把“痛”变成了“爽”。
有宝妈试过说:“以前擦油烟机得拆滤网、泡热水、戴手套,现在喷一喷、擦两下,10分钟搞定,手一点不疼。”还有网友算过账:“以前每月买3瓶清洁剂,现在1瓶顶3瓶用,还不用频繁换抹布,省的不止是钱,更是时间。”
这波操作,其实戳中了一个更深层的需求:科技不是越复杂越好,而是要解决“最日常的麻烦”。
当厨房从“细菌战场”变回“温馨小灶”,当擦灶台不再是“体力活”而是“轻松事”,这才是真正的“科技改变生活”。
下次做饭前,不妨看看抽油烟机上的油垢——它们曾经是健康的隐患,现在却成了“黑科技”的试金石。
毕竟,能让“烟火气”更安心的,从来不是完美的厨房,而是不断进步的生活智慧。